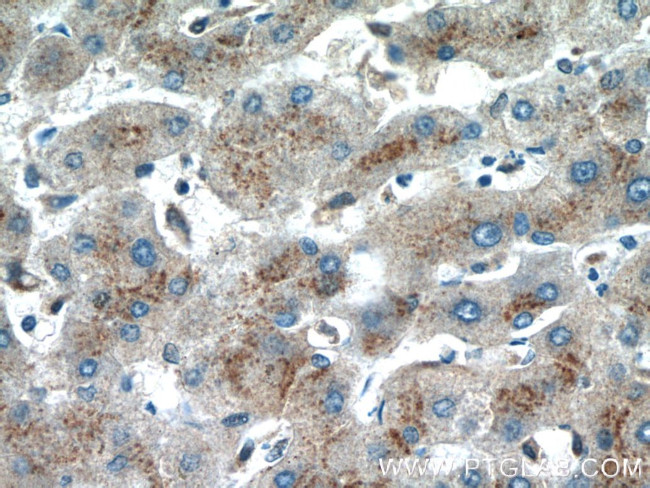
FUCA2 Antibody in Immunohistochemistry (Paraffin) (IHC (P))

Search
Proteintech
FUCA2 Polyclonal Antibody
{{$productOrderCtrl.translations['antibody.pdp.commerceCard.promotion.promotions']}}
{{$productOrderCtrl.translations['antibody.pdp.commerceCard.promotion.viewpromo']}}
{{$productOrderCtrl.translations['antibody.pdp.commerceCard.promotion.promocode']}}: {{promo.promoCode}} {{promo.promoTitle}} {{promo.promoDescription}}. {{$productOrderCtrl.translations['antibody.pdp.commerceCard.promotion.learnmore']}}
产品信息
15157-1-AP
种属反应
宿主/亚型
分类
类型
抗原
偶联物
形式
浓度
规格
纯化类型
保存液
内含物
保存条件
运输条件
产品详细信息
Immunogen sequence: SGAKYIVLT SKHHEGFTLW GSEYSWNWNA IDEGPKRDIV KELEVAIRNR TDLRFGLYYS LFEWFHPLFL EDESSSFHKR QFPVSKTLPE LYELVNNYQP EVLWSDGDGG APDQYWNSTG FLAWLYNESP VRGTVVTNDR WGAGSICKHG GFYTCSDRYN PGHLLPHKWE NCMTIDKLSW GYRREAGISD YLTIEELVKQ LVETVSCGGN LLMNIGPTLD GTISVVFEER LRQVGSWLKV NGEAIYETYT WRSQNDTVTP DVWYTSKPKE KLVYAIFLKW PTSGQLFLGH PKAILGATEV KLLGHGQPLN WISLEQNGIM VELPQLTIHQ MPCKWGWALA LTNVI (124-467 aa encoded by BC003060)
靶标信息
FUCA2 (Alpha-L-fucosidase) catalyzes the hydrolysis of terminal alpha-L-fucosidase linkages in glycosphingolipids and glycoproteins. At least 2 separate polymorphic alpha-L-fucosidases are recognized in man. The FUCA2 locus regulates the level of alpha-fucosidase in plasma and fibroblasts but not in leukocytes. In fucosidosis, deficiency of alpha-L-fucosidase is found in both plasma and leukocytes.
仅用于科研。不用于诊断过程。未经明确授权不得转售。
篇参考文献 (0)
生物信息学
蛋白别名: a-L-fucosidase 2; Alpha-L-fucosidase 2; Alpha-L-fucoside fucohydrolase 2; fucosidase, alpha-L- 2, plasma; I+/--L-fucosidase 2; MGC1314; Plasma alpha-L-fucosidase; plasma fucosidase; unnamed protein product
基因别名: 0610025O11Rik; 5530401P20Rik; dJ20N2.5; FUCA2; PSEC0151; UNQ227/PRO260
UniProt ID: (Human) Q9BTY2, (Mouse) Q99KR8, (Rat) Q6AYS4
Entrez Gene ID: (Human) 2519, (Mouse) 66848, (Rat) 292485